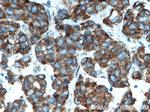
PTRH2 Antibody in Immunohistochemistry (Paraffin) (IHC (P))

Search
Proteintech
PTRH2 Polyclonal Antibody
{{$productOrderCtrl.translations['antibody.pdp.commerceCard.promotion.promotions']}}
{{$productOrderCtrl.translations['antibody.pdp.commerceCard.promotion.viewpromo']}}
{{$productOrderCtrl.translations['antibody.pdp.commerceCard.promotion.promocode']}}: {{promo.promoCode}} {{promo.promoTitle}} {{promo.promoDescription}}. {{$productOrderCtrl.translations['antibody.pdp.commerceCard.promotion.learnmore']}}
产品信息
51006-2-AP
种属反应
宿主/亚型
分类
类型
抗原
偶联物
形式
浓度
规格
纯化类型
保存液
内含物
保存条件
运输条件
产品详细信息
Immunogen sequence: MPSKSLVME YLAHPSTLGL AVGVACGMCL GWSLRVCFGM LPKSKTSKTH TDTESEASIL GDSGEYKMIL VVRNDLKMGK GKVAAQCSHA AVSAYKQIQR RNPEMLKQWE YCGQPKVVVK APDEETLIAL LAHAKMLGLT VSLIQDAGRT QIAPGSQTVL GIGPGPADLI DKVTGHLKLY (1-180 aa encoded by BC006807)
靶标信息
The protein encoded by this gene is a mitochondrial protein with two putative domains, an N-terminal mitochondrial localization sequence, and a UPF0099 domain. In vitro assays suggest that this protein possesses peptidyl-tRNA hydrolase activity, to release the peptidyl moiety from tRNA, thereby preventing the accumulation of dissociated peptidyl-tRNA that could reduce the efficiency of translation. This protein also plays a role regulating cell survival and death. It promotes survival as part of an integrin-signaling pathway for cells attached to the extracellular matrix characterized by intellectual disability, postnatal microcephaly, progressive cerebellar atrophy, hearing impairment, polyneuropathy, failure to thrive, and organ fibrosis with exocrine pancreas insufficiency. Alternative splicing results in multiple transcript variants encoding different isoforms.
仅用于科研。不用于诊断过程。未经明确授权不得转售。
篇参考文献 (0)
生物信息学
蛋白别名: Bcl-2 inhibitor of transcription; Bcl-2 inhibitor of transcription 1; cilia and flagella associated protein 37; OTTHUMP00000205936; Peptidyl-tRNA hydrolase 2, mitochondrial; PTH 2; unnamed protein product
基因别名: A230072I16Rik; BIT1; CFAP37; CGI-147; IMNEPD; PTH; PTH 2; PTH2; PTRH2; RGD1306819
UniProt ID: (Human) Q9Y3E5, (Mouse) Q8R2Y8
Entrez Gene ID: (Human) 51651, (Rat) 287593, (Mouse) 217057